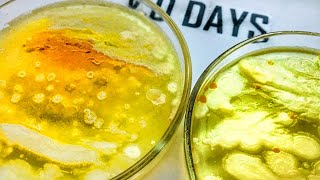

КАК ВЫРАСТИТЬ КЛУБНИКУ ЗИМОЙ
Как вырастить клубнику зимой?
Выращивание клубники зимой может представлять определенные трудности, так как это растение обычно предпочитает теплый сезон для своего роста и плодоношения. Однако, с помощью некоторых техник и инноваций, можно попытаться создать оптимальные условия и получить урожай клубники в зимний период.
Для начала, необходимо выбрать подходящий сорт клубники, который может адаптироваться к зимним условиям. Интересуются сортами, которые более устойчивы к низким температурам и могут продолжать расти при неблагоприятных погодных условиях.
Следующим шагом является создание искусственного климата, который будет подходящим для процессов роста клубники. Для этого можно использовать теплицу или другую защищенную конструкцию, которая будет обеспечивать необходимую температуру и освещение. Контроль влажности также играет важную роль в успешном выращивании клубники зимой.
Определенные типы источников света, такие как специальные фитолампы или светодиоды, могут быть использованы для поддержания оптимального освещения в течение дня. Длительность и интенсивность света должны быть настроены в соответствии с потребностями клубники.
Важно также помнить о правильном поливе растений. Зимой воздух часто более сухой, поэтому необходимо поддерживать умеренную влажность в теплице или другом месте, где вы выращиваете клубнику. Однако следует избегать переувлажнения и застоя воды, так как это может привести к различным проблемам.
Некоторые садоводы также применяют технику подогрева почвы для поля клубники зимой. Это может помочь сохранить оптимальную температуру корней и способствовать более успешному росту.
Вывод: выращивание клубники зимой требует дополнительных усилий и знаний, но с помощью подходящих сортов, искусственного климата и учета всех необходимых факторов, это возможно.
Почему я отказалась от черного спанбонда на клубнике. Первые работы весной на грядке с клубникой
Клубника на подоконнике Как вырастить клубнику зимой на подоконнике? strawberries on the windowsill
ПОДЗЕМЕЛЬЕ ДЛЯ ЗИМНЕГО ВЫРАЩИВАНИЯ / ПОДЗЕМНАЯ ТЕПЛИЦА 100 / ВЫРАЩИВАНИЕ КЛУБНИКИ, ЛУКА,ОГУРЦОВ/ DIY
Как выращивать клубнику круглый год? Основные ошибки.
Клубнику зимой начали выращивать в Алматинской области
Малообъемка для начинающих.Часть 2:УРОЖАЙ